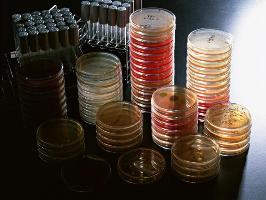

|
さて植物は、セルロースとヘミセルロースという2種類の糖の繊維からできています。セルロースは、分解するとブドウ糖になりますが、分解するのが大変に難しいのです。一方、ヘミセルロースは、分解するのはセルロースより簡単なのですが、できてくるキシロースなどを利用する細菌は極めて少ないのです。
このような事柄だけを考えても、生ゴミを処理する微生物を見つけ出すことは、そんなに簡単なことではないのです。さらに処理するだけでなく水素を作る能力ももっていないとならないのです。廃棄物を処理しながら水素を作れる細菌をどうすれば見つけ出せるのでしょうか。
4−2.有望な候補菌
どのような種類の細菌が目的対して有望なのか、またどこからその水素生成菌を分離するのか、さらにどのような条件を用いれば分離できるかなど、未知な問題を一つずつ解決しなければなりません。そのような微生物を分離する際に考えた「期待値」について概略を説明しましょう。
望ましい細菌
1.水素ガスを生成する微生物を増殖させると、発生する水素により栄養液中に溶存している酸素は水素により消失し、微生物の増殖する環境は完全な嫌気状態になるであろう。したがって、目標とする微生物は、酸素がなくても増殖できる通性嫌気性菌か嫌気性菌が適当と思われる。
2.目的とする微生物は、熱や光をはじめ物理化学的刺激に対して抵抗性が強いもの、ならびに保存することが容易な菌が望ましい。したがって、耐久性の細胞である芽胞を作る細菌が望ましい。
3.水素を生成する基質として、セルロース、ヘミセルロースまたはスターチ、キシランなどの高分子を利用できる微生物、すなわち高分子物質を分解するセルラーゼ、ヘミセルラーゼ、アミラーゼやキシラナーゼなどの酵素群を産生し、かつ菌体外への分泌能を有する菌であることが望ましい。したがって、Clostridium属やBacillus属の細菌が望ましいであろう。
4.水素生成微生物の探索源としては、分類学的に古い無脊椎動物に属し木材や家屋をも食う昆虫、すなわちシロアリが適当であるかもしれない。
5.目的の微生物を探索するための培養条件として、嫌気性菌であってもあまり強い嫌気度を必要としない条件、すなわち市販の嫌気性培養フラン器で簡単に増殖できる範囲の嫌気性菌種が適当である。メタン生成菌のように生育に強い嫌気度を必要とすると簡単に取り扱えなくなるからであります。
6.目的菌を探索するための培養条件としての培地は、できるだけ低栄養価(貧栄養)にし、通常の大腸菌などの腸内細菌の増殖を抑制できるものが適当かもしれない。
7.目的菌の培養条件としての温度は、廃棄物処理に多量なエネルギーを消費しないために、中温菌の発育限度の40℃程度までが適当であろう。高温菌の方が反応速度は速いので将来は高温水素生成菌の探索も必要となろう。
5.シロアリは水素を作る細菌を飼っているに違いない
5−1.シロアリとは面白い
この章の最初「はじめに」に熱帯雨林の上空には高濃度のメタンガスや水素ガスが検出される話を書きました。この話は、土壌科学(Soil sciences)の研究者の主張で、立派な学術雑誌に掲載されていたのです。その報告者は、メタンガスや水素ガスはシロアリが作っているとも指摘していました。
昆虫に関する本に「シロアリは蟻にあらず、ゴキブリの仲間だ、ゴキブリは分類学的にはとてつもなく古い動物だ」などと書いてあるのを偶然に見つけました。シロアリは白いアリかと思ったら蟻でなくゴキブリとは面白いではないですか。一般的にシロアリは、代表的な害虫の1種です。なぜ害虫なのかというと、家屋を含めて木造物を食いつぶすからで、セルロースを分解して喰ってしまうからです。セルロースを食って水素を作り、その水素からメタンを作っていると仮定すると、シロアリは面白い対象物と考えられます。
シロアリ駆除を業務とする会社に就職している卒業生にシロアリが欲しいのだが、どうすれば手に入れられるかを聞いてみました。すると自分の会社では研究用にシロアリを飼育しているので、必要なら幾らでも無償で提供できるといってくれました。どれくらい希望ですかと聞かれて、数百匹あれば充分と答えました。プラスチックのバケツに入れておいても、プラスチックを食って逃げ出しますから注意してもらわないと困ることになる可能性がありますとも言われてしまいました。度々貰いに行くのも面倒ですし迷惑でしょうから、なにか良い方法はありませんか? それならシロアリが住み着いている木をそのまま差し上げます、その木を大き目のポリ容器に入れておけば逃げ出しませんから安心です。
5−2.シロアリ釣り
シロアリが住みついている木をもって来てくれました。木を少し動かしてもその下に白いシロアリがごそごそと動いているのが見えました。早速ピンセットでシロアリを摘みだそうとしました、うまくいきません。ピンセットで摘もうと思っているうちに木の陰に隠れてしまいます、またピンセットで摘めたとしてもシロアリを潰(つぶ)してしまうのです。どうすればシロアリをつまみ出せるのかを電話で聞きました。絵筆でシロアリをなぜるとシロアリは筆先に食らいついてきますので、幾らでも釣り上げられますと面白いことを教えてくれました。
絵筆の先でシロアリ釣を始めました、幾らでも楽々と苦労せずにシロアリを釣り上げ、ガラスのシャーレに取り出すことができるのです。絵筆の先でシロアリを釣るのはとても面白いことでした。シロアリは絵筆の先にどのようにして食らいつくのかをレンズを使って拡大して観察してみました。ものすごい形相をしたシロアリが目に入ってきました。シロアリの頭と同じくらいに口を大きく開いているのです。その様は、カニがハサミを開いて襲い掛かってくる様子と全く同じ構えなのです。絵筆の毛先をハサミで食らいついてくるのです。意地悪くシロアリを怒らせると大きな口を開けてハサミを広げて攻撃してくるかのような様子が観察できました。
5−3.蟻酸(ぎさん)を作るシロアリ
ところがもう少し全体を静かに観察しているうちに、面白いことに気がつきました。シロアリは口を開いているだけでなく、無色透明な水のような液体を口からこぼれんばかりに噴出しているのです。ハサミ(アゴ)を大きく開いて脅かすだけでなく、なにか毒のような液体をハサミの間に抱きかかえているのです。シロアリをガラスシャーレに沢山集めて、その不思議な液体を少し集めてみました。猛毒かもしれないのですが、PH試験紙を細くしてその先端で液体に触れてみました。酸性の液体であることが即座にわかりました。
そこで思わずに大声を出してしまいました、シロアリは蟻酸(アリの酸)を出しているのだ!と。ハチやアリは蟻酸を出すのだ、それだから蟻酸と書くのか、全くバカみたいな発見に心が躍るのでした。
シロアリは蟻酸を作る、蟻酸や水素はメタンの格好な原材料であるのだ。するとシロアリが水素やメタンを作ることは先ず間違いないことと考えられます。「オープン・セサミー、開けゴマ」、ヨーシ、シロアリから水素を作る細菌を探そう!
6.シロアリのジュースからはカビが生えた
ある材料からごく少数存在する特定の細菌を取り出すには、理想的にはその材料を全て使って細菌を探せれば見つけられる可能性は高くなります。しかし、材料を全て調べることは必ずしも容易ではありません。一般的には材料の一部を全体の代表として用いて細菌の分離を試みます。
そのようなことから細菌を単離するときの常套(じようとう)手段として、最初にその材料を均一化して、その一部を使います。シロアリから水素を作る細菌を分離しようとしたとき、シロアリを乳鉢に入れてペースト状の乳剤を作り、これを分離用のサンプルとしました。栄養分を含む寒天をシャーレに注いで平板にした培地にシロアリから作ったサンプルを移植します。この操作を専門家は接種するといいます。サンプルを接種した寒天平板をみとふたを逆さまにして(具体的にはフタを下にミを上にする)、37℃に調整し空気中の酸素を除いてある嫌気性フラン器と普通の空気で満たされている好気性フラン器におさめて細菌の培養を試みました。
一晩保温して翌朝フラン器からシャーレを取り出して、どのような微生物が寒天培地に生えているのかを観察するのです。シロアリの言葉は判りませんが、「今日(こんにち)は赤ちゃん」と呼びかけながら寒天平板の表面を眺めました。寒天の表面には大きさと色が異なる大小さまざまな細菌の集落が観察されると同時に、クモの巣の細い糸のように見えるカビが寒天表面一杯に生えていました。そのカビは、細菌の集落の上も被っていました。カビと細菌が混在している状態からカビだけを取り出すのは比較的に容易なのですが、しかし、細菌のみを取り出すのは結構難しいのです。そのためカビが生えてしまうと、そこから細菌を取り出すことはアキラメル必要があります。
一方、嫌気性フラン器にいれて一晩保温した寒天培地の表面には、細菌と思われる集落はできていませんでした。何回も繰り返して試してみましたが、嫌気性ではほとんど細菌の集落やカビは生えてきませんでした。
もしかするとシロアリを乳鉢で根気よくすり潰して乳剤を作る操作は、考えると空気中の酸素に曝露していることでもあります。もしかすると酸素に曝露してしまうと嫌気性の細菌は寒天表面に生えてこないのかもしれません。空気中の酸素と触れさせないでサンプルを準備するのはどうすればよいのでしょう。少し考えました。
7.シロアリを生き埋めにしろ
7−1.発育しない菌
普通の細菌を培養するような方法を用いて新しく珍しい細菌をシロアリから分離しようと考えたが、常識的な方法では常識的な細菌やカビなどしか生えてこなかった。白っぽい綿くずのようなカビが寒天の表面を覆ってしまった。ところが嫌気性では細菌もカビも生えてこなかった。
シロアリが巣を作っている松の木からシロアリを絵筆の先につけてシロアリ釣をしているときに「あること」に気がつきました。シロアリは前にも書いたように、大きな口を開けそこに蟻酸らしき酸性の液体をホオバッテいる、このことはシロアリは蟻酸に抵抗性であることを示してくれているのだ。これを使わない手はないぞと思いつきました。これは天の声です。
「空気に触れさせないこと」と「蟻酸を含ませること」をうまく組み合わせれば、シロアリからこれまでに見つかってない面白い菌がとれるに違いない。さらに、シロアリの生息している環境および土壌などには、細菌を増やすための培地に含まれているような栄養分の組成と濃度、例えば、土にはブドウ糖などはそれほど高濃度に含まれて居ないはずです。そこで次の実験が成功するように、「開けゴマOpen sesame」とオマジナイをかけました。蟻酸を少量加え栄養分を極端に少なくした蟻酸添加貧栄養寒天培地を作りました。寒天培地の温度が50℃程度の温度にまで冷えたとき、シロアリを寒天液に加え全体をよくかき混ぜました。そのシロアリを含んでいる寒天培地をシャーレに分注して寒天を固まらせました。シロアリは、寒天の表面に乗っかっているのもあれば、寒天のなかに埋もれているのもありました。
寒天にシロアリを生き埋めにしたシャーレを嫌気性フラン器に収納して培養を開始しました。「開けゴマOpen sesame」とオマジナイをかけましたから、秘密の扉は必ず開くと期待しシロアリを生き埋めにしたシャーレを観察するために嫌気性フラン器からシャーレを取り出しました。寒天のなかに生き埋めにしたシロアリはどうなっているのでしょう。期待に反して寒天の表面には、細菌もカビも全然生えてないのです。翌日も期待しながら嫌気性フラン器の扉を開いては、シャーレの表面を眺めました。何の変化もないムナシイ結果でした。
オマジナイは利かなかったのです、シロアリを生き埋めにしたシャーレは消毒して捨てるべき運命にありました。シロアリは無菌であるはずがない、それでもシャーレは無菌的な状態にある。どうしてこうなるのだろうか、少し考えることにしました。考えている間は、シャーレを捨てないで、嫌気性フラン器に入れておきました。
栄養分を極端に少なくした貧栄養寒天培地がシロアリの細菌を増殖するのに適当でないのかもしれない。また蟻酸を加えたのが悪かったのかもしれません。あまり極端に栄養分を少なくしないで、もう少しだけ栄養分を加えて再度試験をやり直すことに決めました。それで2週間前にフラン器に入れたシロアリの生き埋め寒天を処分しようと、フラン器から取り出しました。
7−2.遅発育菌
1週間前までは寒天表面には何の変化も見られなかったシャーレに驚くような事が現れたのです。寒天のなかに生き埋めになったシロアリおよび寒天の表面にのっているシロアリの体の周囲、特にオシリの周囲には噴出したかのように1ミリもの大きさの細菌の塊らしき白い物が観察されました。捨てるはずのシャーレにシロアリから細菌らしきものが噴出してきているのです、予期せぬ出来事に驚きました。
急いで新しく蟻酸を加えた貧栄養寒天培地を作り、シロアリの体の周りに観察される白っぽいものを、新しい寒天培地に塗りたぐりました(1枚のシャーレにできている細菌の集落を別な新しいシャーレに塗ることを継代培養と呼びます)。ここから先の操作は、細菌を分離する常套手段に属する技術で特段に目新しいことは何もありません。細菌が集団で増殖していても、小さな面積の範囲で増えていると、本当はそこに10種類の異なる細菌が存在するにしても、そこに存在する細菌全てが一塊になって見えます。その塊として混在している細菌を別々に分ける必要があります(この別々に分ける操作を純培養にすると呼びます)。
細菌を分別する目的で新しいシャーレに継代培養すると同時に分離培養を試みたのです。一匹のシロアリのオシリのところに増殖していた一塊の細菌集団を新しい二枚の寒天に塗沫しました。この操作を全てのシロアリについて行ないました。シャーレはフラン器にいれて培養しました。翌朝は新しい出来事に対する期待値で心臓がドキドキするのが聞こえるようでした。「慌てる乞食は貰いが少ない」とはやる気持ちを抑えながらフラン器からシャーレの山を取り出しまた。一晩培養しただけでは、また針先程度の小さな集落らしきものしか見えませんでした。もう1日培養することにしました。
精神的にも肉体的にも「盆と正月が一緒に来たような忙しさ」が突然に訪れてきました。全てのシャーレに何がしかの細菌らしきものの集落が明瞭に観察されるのです。針先くらいに小さな集落から1ミリほどの大きさの集落、真ん丸な集落もあれば周囲がギザギサしている集落、表面がツヤツヤと輝いている集落もあれば乾いてカサカサしているような集落、集落のなん中が盛り上がっているものもあれば真ん中が平らな集落、集落の色も紫色、黄色、紅色、白色などと変化し、透明な集落もあれば不透明な集落も肉眼的に見られます。ここに書いたような集落の特徴が組み合わされるのですから、外観的に100種類くらいの異なる集落が見てとれました。これは凄いぞー。
サンプルを接種した寒天培地 細菌集落の識別と符号付
7−3.菌株の識別
集落の一つ一つを識別するために番号をつけ、お前さんはAの一番、貴方はAMの一番、君は蟻酸のFを着けF50番などと名前を呼びながら、作業を進めていきました。これが楽しいひと時となります。一つの集落を新しい寒天培地に継代し、1枚のシャーレに1種類の集落になるまで継代を繰り返し、純粋に1種類の細菌になるまで培養を繰り返します。この操作をいい加減にすると後で大変なシッペ返しを食らいます。シャーレの数は、瞬く間に数百枚になってしまいました。
蟻酸を添加した貧栄養寒天培地は、予想以上によく働いてくれました。蟻酸を加えたことで大腸菌のような普通の細菌やカビの類いの発育が抑制されたのです。さらにブドウ糖などを少なくした貧栄養寒天培地は、普通の発育のよい細菌の増殖には不向きなので、発育してきた細菌はシロアリの体の周囲に限定されていました。シロアリのオシリの先端から噴出しように細菌の塊ができていたことは、シロアリの体内で増えた細菌がオシリから噴出してきたのかもしれない。「開けゴマ」とのオマジナイは面白い結果を運んできてくれました。シロアリからの形相の違う細菌達は、勝手にオシャベリを楽しんでいるように、外観の違いを競っているように見えます。この連中は何語をシャベッテいるのだろうか。鼻を近づけてニオイをかいで見る。
8.シロアリ菌を選別せよ
8−1.水素産生能
シロアリから分離した細菌150株ほどを純粋に単一の培養にすることができました。この150株の細菌は、とのような性状の細菌なのかを調べ、その性質から分類的にどのような細菌(専門的には分類学的な属)に属するのかを決め、更に属より下の分類項目の種まで決める必要があります。このような操作を専門的には分離した細菌を同定すると言います。
赤痢やコレラなどのような典型的な細菌による感染症の原因菌を分離して同定する手順は、100年ほど前の先輩たちが作り上げてくれています。そのため典型的な病原菌の分離と同定は、専門家にするとそれほど難しい問題ではありません。しかし、破傷風やガス壊疽などの原因菌は、嫌気性細菌と呼ばれる細菌群ですから、取り扱う環境から培養する装置までもが酸素を取り除いた状況でなければ増殖しません。嫌気度の強さによりますが、そのために嫌気性菌を取り扱うのは「嫌気(いやけ)」がさすほど面倒なのです。
私達は、米国製のグローブボックスと呼ぶ、パラジウムで酸素を取り除く特別な装置
がついている箱型で気密性の高い培養装置を使い、箱の前面に取り付けられている酸素
を透過させない特殊なゴム手袋を使って箱のなかでの作業をしました。グローブボック
スのなかは、嫌気度を保つために水素10%、二酸化炭素10%と窒素80%の混合ガ
スを充満させてあります。
150株ほどシロアリから分離した細菌を常識的には同定する必要はあるのですが、貴重な時間と大金を使って分離菌を同定したら、「大腸菌の仲間やブドウ球菌でした」では結果としては水素発酵の今後の研究には不要な菌株であったことになります。そこで試験の順番を逆にして、未同定のままにして、各菌株の水素を出す性能を先に調べることにしました。
シロアリから分離した菌株が水素ガスを作る能力があるかないかの有無をどう調べたらよいのでしょう。このような教科書に答えが記載されていない問題に直面したとき、どのように解決したらよいか困惑することもしばしばありますが、反面この壁を乗り越えないと前に進まないのですから、必然的に闘争心が湧いてくるものです。問題が難しければ難しいほど闘争心は大きくなります。結果として問題が解決されたときの喜びは言葉では表現できない喜びが沸きあがります。
「3.水素ガスを作ることを証明するにはどうするのですか」に糖分解能試験という実験法について書きました。大腸菌はブドウ糖を分解し二酸化炭素を作ります。ブドウ糖を寒天の入った培地を試験管に入れて固めます。大腸菌をつけた針(専門的には白金線と呼ぶ)を固まった寒天に差し込み(接種すると呼ぶ)、フラン器にいれて保温します。すると二酸化炭素が作られるので、ガスの圧力で寒天に亀裂が入ります。この亀裂の有無でガスの産生能を判定できるのです。
8−2.糖分解試験
この試験法を利用してシロアリから分離した菌株の水素の生成能を調べることにします。ブドウ糖を含む寒天培地を小試験管にいれて固める場合、少し考えました。2.5mlの寒天をいれて試験管を斜めにして寒天を固める(この形を斜面培地といいます)のと3mlの寒天をいれて試験管を立てたまま寒天を固める(高層培地といいます)のとどちらが目的に合うかなのです。少しでもガスを出すことを知りたいのであれば、斜面寒天培地を使えば良さそうです。少量のガスを作ったのは判断できなくても、抵抗性から作られたガスの圧力がある程度かからないと亀裂が見えにくい高層寒天培地を使えば陽性率は低くなるかもしれませんが、少しでも大量にガスを作る菌を選びたいときには高層培地を使えば良さそうと考えました。
新しい性質の微生物を見つけだす仕事は、抗生物質などの医薬品、酵素や調味料などの開発研究の現場ではどこでも実施されていることで、珍しいことではありません。しかし、珍しい宝物、例えば、ダイアモンドや金などを作る微生物を探す場合には、1万株から10万株もの菌株を調べても一株も見つけられないことも珍しくありません。普通は非常に根気と忍耐力のいる仕事になりますから、人によってはその単調さに耐えられないのです。1万株の微生物から宝物を探す場合、結果として見つけ出せれば成功なのですから、ある人がその探索を始めるときは左から右に規則正しく調べて行きます。また別な人は全くランダムに上下左右無秩序に調べていく人もいます。目的に適う微生物が必ず1万株のなかに含まれていると解っているケースでも、ある人は一番あとの1万回目に目的地に到達する人もいる反面、最初の10番目くらいに成功してしまう幸運な人も現にいるのです。私はこの幸運を呼び込める人を「ゴールド・フィンガー」の持ち主または「魔法の手」をもつ幸運者と呼んでいます。
8−3.150株のスクリーニング
名前をつけた150株のシロアリから分離した菌株のガス生産能を寒天の亀裂を指標として試験(一次スクリーニングと呼ぶ)した結果、135株(90%)のシロアリ菌が水素ガスらしいガスを作ることが判明しました。この135菌株がたはして水素ガスを作っているのかを調べる必要があります。ブドウ糖を含む培地から発生したガスの組成を特殊な分析機を使って分析しました。ガス分析では、水素の存在とその濃度並びに悪臭物質として有名な硫化水素の存在なども丁寧に調べました。硫化水素を作る細菌を除き100株(67%)が水素を作ることが判りました。
驚くべき高率で水素を作る細菌が手に入ったのです。前にも簡単には触れましたが、薬をつくる菌、酵素をつくる菌など特定の機能をもった有用菌の検索は、とても忍耐力と体力を要する仕事なのです。それは、1万回か10万回に1回程度の確率でしか的にあたらないからです。それが数拾パーセントの確率で水素をつくる菌が手に入ったのです。万々歳です。
9.シロアリ菌を増やしたフラスコが爆発した
9−1.水素ガスの集め方
100菌株がたはしどのくらいの量の水素ガスを作っているのかを最初に調べました。ブドウ糖を入れたコンソメスープ(専門的にはブイヨンと呼ぶ)を三角フラスコにいれて雑菌を死滅させるために高圧蒸気滅菌をします。一個のフラスコに一株の菌を接種して一晩37℃で培養します。そのときフラスコにはゴム栓をつけ、そのゴム栓に太い注射針を差し込み、注射針の頭にビニールチューブをつけました。水が入っているバケツのような容器のなかで水を口まで一杯にいれた100mlのメスシリンダーを逆さまにし、そのシリンダーにチューブの先端を差し込みました。水上置換法という簡単な方法でガスを定量的に捕集するのです。
さてどのくらいの量のガスが作られているのかを観察する瞬間が来ました。緊張しワクワクする気持ちでフラン器の扉を開けました。フラン器の棚のうえで何本かの100mlのシリンダーは、引っくり返ってしまっていました。ガスがたくさん作られた結果、100mlのシリンダーから溢れてしまったのです。また別なシリンダーには、20mlから60mlの気体が入っているのが観察されました。これはすごいことになりそうな感じがしました。シリンダーを上下逆さまにしてシリンダーの口にライターの火を近づけると「ポーン」と音をだして燃えました。その音の大きさは、ガスの量によって違いました。ガスが80mlも入っているシリンダーでは大きな爆発音がしますが、20ml程度ではポンで終わりです。
9−2.17%の分離成功率
これで水素ガスが数10ml作られている可能性が判りました。ただし、ひっくり返ってしまったシリンダーの三角フラスコに接種した菌株は、100ml以上であるのですが、何mlの水素ガスを作ったのかは判りませんでした。このガス産生試験の結果から、ガス量の多い順に50株(34%)を選び出しました。
ここで50株のシロアリ菌がブドウ糖以外のどのような糖質から水素を作れるかも調べました。例えば、ブドウ糖、キシロース、セロビオース、乳糖、スターチ、キシラン、デキストラン、セルロースなどのような物質から水素を作れるかを一株ずつシラミつぶしに調べていきました。25株(17%)が一次スクリーニングの結果、多種類の糖質から水素を作れる優良菌の候補として残りました。水素ガスをつくる一次候補の菌株が150株から25株(17%)も手に入ったのです。
9−3.人類初の体験
いよいよ試験はクライマックスの域に入ります。25株の一次優良菌の水素ガス産生能を定量的に測定して、菌株の最終絞込みをする段になりました。ブドウ糖を1%に含ませたブイヨン1,000mlを1リットルの三角フラスコに入れ、そこに調べるべき菌株を接種しました。10グラムのブドウ糖から作られる水素の量を定量するのです。産生される水素量は、どのていどなのかの推測もできないので、内容積が1リットルの特殊なフラスチック製袋を装着して、フラン器内で一晩培養しました。
シロアリから分離した細菌は、10グラムのブドウ糖から何mlの水素を作るのでしょう。これまでにこの類いの経験をした人はいないのです。心が躍ります。この地球に生まれ育った500億人の人類史上初めての結果を観察できるのですから。1リットルの袋が適当に膨らんでいることを期待して、サァーとフラン器の扉を開きました。フラン器の内壁を作っているこがね色の銅版を背に三角ラスコがありました。なんたることでしょう、超硬質ガラス製の三角フラスコが粉々に割れて、菌液がフラン器じゅうに飛び散っているのです。無傷で残ったフラスコも勿論ありました。残ったフラスコの頭につけられているフラスチック製袋は、少し膨らんでいるものから、パンパンに膨らんでいるものまで様々でした。内容積が1リットルの特殊な袋がパンパンに膨れている三角フラスコが一番手前に残っていました、それに手を伸ばしてフラン器から取り出そうとしたその瞬間です、超硬質三角フラスコは私の胸の前で大爆発を起こしたのです。菌液もガラス片も完全に飛び散りました。着ていた白衣は菌液で黄色のシミができ、作業用のズボンは濡れてしまいました。フラスコは顔の位置より少し下にして持っていたので、顔にガラス片があたらなかったことは不幸中の幸いでした。
この爆発したときの菌は、AM21Bという名前をつけた菌株でした。あとで判明したことは、10グラムのブドウ糖から作られた水素ガスは、1リットル以上もの量になり、1リットルの袋では容積が不足で、ガラスの三角フラスコを破壊したのでした。最終的にAM21B株のシロアリ菌は、10グラムのブドウ糖から4リットル程度の水素ガスを作っていました。超硬質のガラス製三角フラスコを粉々に破壊したシロアリ菌は、5株でした。この5株のシロアリ菌が私の分身で廃棄物から水素ガスを作る世界的にも珍しい宝物となりました。
10.シロアリ菌は世界最速の水素製造菌だ
シロアリから分離した水素を作る細菌は、嫌気性でグラム染色をすると黒紫に染まるグラム陽性で芽胞を作る桿菌であることが判りました。そのなかの1株の細菌は、分類学的にはClostridium beijerinkii と呼ばれ、チーズを作る細菌に性質が似ていることが解りました。この細菌の固有名を実験番号からAM21B株と名づけました。
 破傷風菌やガス壊疽菌などの嫌気性菌を培養すると、耐えられないような悪臭を放ちます。これは嫌気性菌の一般的な性質で、タンパクから硫化水素、アンモニアやアミン系の物質を作るからなのです。ところがシロアリ菌の洗礼を受け、大袈裟に表現すると全身がシロアリ菌の培養液で濡れてしまったのです。細菌を扱っている人にこのような話をすると、「直ぐに臭くて大変でしたでしょう」と言われます。 破傷風菌やガス壊疽菌などの嫌気性菌を培養すると、耐えられないような悪臭を放ちます。これは嫌気性菌の一般的な性質で、タンパクから硫化水素、アンモニアやアミン系の物質を作るからなのです。ところがシロアリ菌の洗礼を受け、大袈裟に表現すると全身がシロアリ菌の培養液で濡れてしまったのです。細菌を扱っている人にこのような話をすると、「直ぐに臭くて大変でしたでしょう」と言われます。
シロアリ菌の電子顕微鏡写真
ところがAM21B菌は、親孝行な細菌で、親を困らせるようなことはしませんでした。上にClostridium beijerinkii は、チーズを作る細菌に性質が似ていると書きました。全身からチーズのような香りがしましたが、鼻をつまむほど強烈な臭いを放つことはありませんでした。
AM21B株は、ブドウ糖を加えたブイヨンに接種して37℃に保温すると、培養開始2時間頃より水素ガスの発生が白い泡として観察されだし、そのガスの発生はそのご急激に増大し、5時間から6時間頃に単位時間に作られるガス量は最大値に達し、その後は時間の経過とともに少なくなり10時間頃にガスの発生はほとんどなくなりました。
酵母によるアルコールの産生やメタン菌によるメタンガスの産生にと比べると、AM21B株の水素ガスの産生は桁外れに速いことがわかりました。例えば、ブドウ糖からアルコールのでき方を図に表すと横軸は1日、2日、3日と24時間単位の日で長さを表し、アルコールの産生は一週間くらいの反応時間が必要となります。それに比較して、AM21B株による水素ガスの生産の横軸は、何時間と時間の単位であり、2時間頃から立ち上がり、5〜6時間頃がピークとなり、10時間程度で終息するパターを描きます。ピーク時の高さが反応速度を表し、この高さが高いほど水素ガスを作る速度が速いことを意味します。
色々な試験の結果、これまでに水素ガスを作ると報告されている光合成微生物と比べるとAM21B株は数千倍ほど水素ガスを作る反応速度が速いことが判りました。AM21B株の水素ガスの生成速度は世界中の微生物のなかでも最も速い部類に入ることも判りました。世界最速の水素生成菌が手に入ったのです。このような喜びを味わえるのは、実験者の特権です。研究はドラマなのです。
11.シロアリ菌は廃棄物処理菌に最適だ
シロアリ菌がどのような物質からどのような化学反応を経て水素ガスを作るのかは、必ずしも明確ではありません。これまでの経験から判断すると、砂糖のような糖類から大量な水素を作ることは間違いないようです。それではどのような糖類から水素を作れるのかを調べてみることにします。
表 シロアリ菌の食べ物
|

 地球に存在する空気は、その組成としては窒素ガスと酸素ガスが主な物質であり、水素ガスはほとんど存在しないはずです。また単位重量あたり石油の3倍もの潜在エネルギーをもち、瞬間的に酸素と結合するクリーンなエネルギー源と期待されている水素ガスがなぜ熱帯雨林のジャングルの上空で検出されるのでしょう。空気より重いエーテルや硫化水素と違って、水素は非常に軽い物体ですから、地表よりたかい場所で検出されることは理にかなっているのでしょう。燃焼しても水しかできない究極のクリーンなエネルギーである水素ガスがどうして、予想もつかない奇妙な場所に存在するのでしょうか、不思議な話です。
地球に存在する空気は、その組成としては窒素ガスと酸素ガスが主な物質であり、水素ガスはほとんど存在しないはずです。また単位重量あたり石油の3倍もの潜在エネルギーをもち、瞬間的に酸素と結合するクリーンなエネルギー源と期待されている水素ガスがなぜ熱帯雨林のジャングルの上空で検出されるのでしょう。空気より重いエーテルや硫化水素と違って、水素は非常に軽い物体ですから、地表よりたかい場所で検出されることは理にかなっているのでしょう。燃焼しても水しかできない究極のクリーンなエネルギーである水素ガスがどうして、予想もつかない奇妙な場所に存在するのでしょうか、不思議な話です。
 ドブのような汚い淀(よど)んだ水の表面からメタンガスの泡がヘドロから湧き出しているところを見たことがあると思います。珍しい現象ではありません。廃棄物の埋立地からもメタンガスが発生し、火災の原因になることも珍しいことではありません。
ドブのような汚い淀(よど)んだ水の表面からメタンガスの泡がヘドロから湧き出しているところを見たことがあると思います。珍しい現象ではありません。廃棄物の埋立地からもメタンガスが発生し、火災の原因になることも珍しいことではありません。
 それで「ぶどう酒の絞り粕」を処理するにはA菌、B菌とC菌を使えばよい、残飯処理にはA菌、X菌、Y菌とZ菌が適していると適材適所に菌種を使い分けられれば、素晴らしい廃棄物の処理法が誕生するはずと考えました。
それで「ぶどう酒の絞り粕」を処理するにはA菌、B菌とC菌を使えばよい、残飯処理にはA菌、X菌、Y菌とZ菌が適していると適材適所に菌種を使い分けられれば、素晴らしい廃棄物の処理法が誕生するはずと考えました。
 ヘドロに存在していた水素ガスを作る細菌群を30リットルの大きなフラスコ内に閉じ込めることができたのです。この容器内の底に沈殿しているヘドロまたは液体から水素を作る細菌を取り出せればよいのです。特定の細菌を取り出すことを専門的には「細菌を分離する」と言います。細菌を分離するという作業は、不特定多数の細菌群が生息している集団から特定の性質の細菌を選び出す一連の細菌の集落を拡大して観察操作を言います。
ヘドロに存在していた水素ガスを作る細菌群を30リットルの大きなフラスコ内に閉じ込めることができたのです。この容器内の底に沈殿しているヘドロまたは液体から水素を作る細菌を取り出せればよいのです。特定の細菌を取り出すことを専門的には「細菌を分離する」と言います。細菌を分離するという作業は、不特定多数の細菌群が生息している集団から特定の性質の細菌を選び出す一連の細菌の集落を拡大して観察操作を言います。 大腸菌を植えた試験管では、ブドウ糖寒天培地も乳糖寒天培地も2本とも寒天の色が赤色から黄色に変色し、さらに試験管に詰めてある寒天に亀裂が入り、寒天が試験管のなかで少し浮き上がっているのが判りました。一方、赤痢菌を植えた寒天培地では、乳糖寒天培地は赤い色のままで何の変化も認められませんが、ブドウ糖寒天培地は赤色から黄色に変色していました。
大腸菌を植えた試験管では、ブドウ糖寒天培地も乳糖寒天培地も2本とも寒天の色が赤色から黄色に変色し、さらに試験管に詰めてある寒天に亀裂が入り、寒天が試験管のなかで少し浮き上がっているのが判りました。一方、赤痢菌を植えた寒天培地では、乳糖寒天培地は赤い色のままで何の変化も認められませんが、ブドウ糖寒天培地は赤色から黄色に変色していました。

破傷風菌やガス壊疽菌などの嫌気性菌を培養すると、耐えられないような悪臭を放ちます。これは嫌気性菌の一般的な性質で、タンパクから硫化水素、アンモニアやアミン系の物質を作るからなのです。ところがシロアリ菌の洗礼を受け、大袈裟に表現すると全身がシロアリ菌の培養液で濡れてしまったのです。細菌を扱っている人にこのような話をすると、「直ぐに臭くて大変でしたでしょう」と言われます。
破傷風菌やガス壊疽菌などの嫌気性菌を培養すると、耐えられないような悪臭を放ちます。これは嫌気性菌の一般的な性質で、タンパクから硫化水素、アンモニアやアミン系の物質を作るからなのです。ところがシロアリ菌の洗礼を受け、大袈裟に表現すると全身がシロアリ菌の培養液で濡れてしまったのです。細菌を扱っている人にこのような話をすると、「直ぐに臭くて大変でしたでしょう」と言われます。